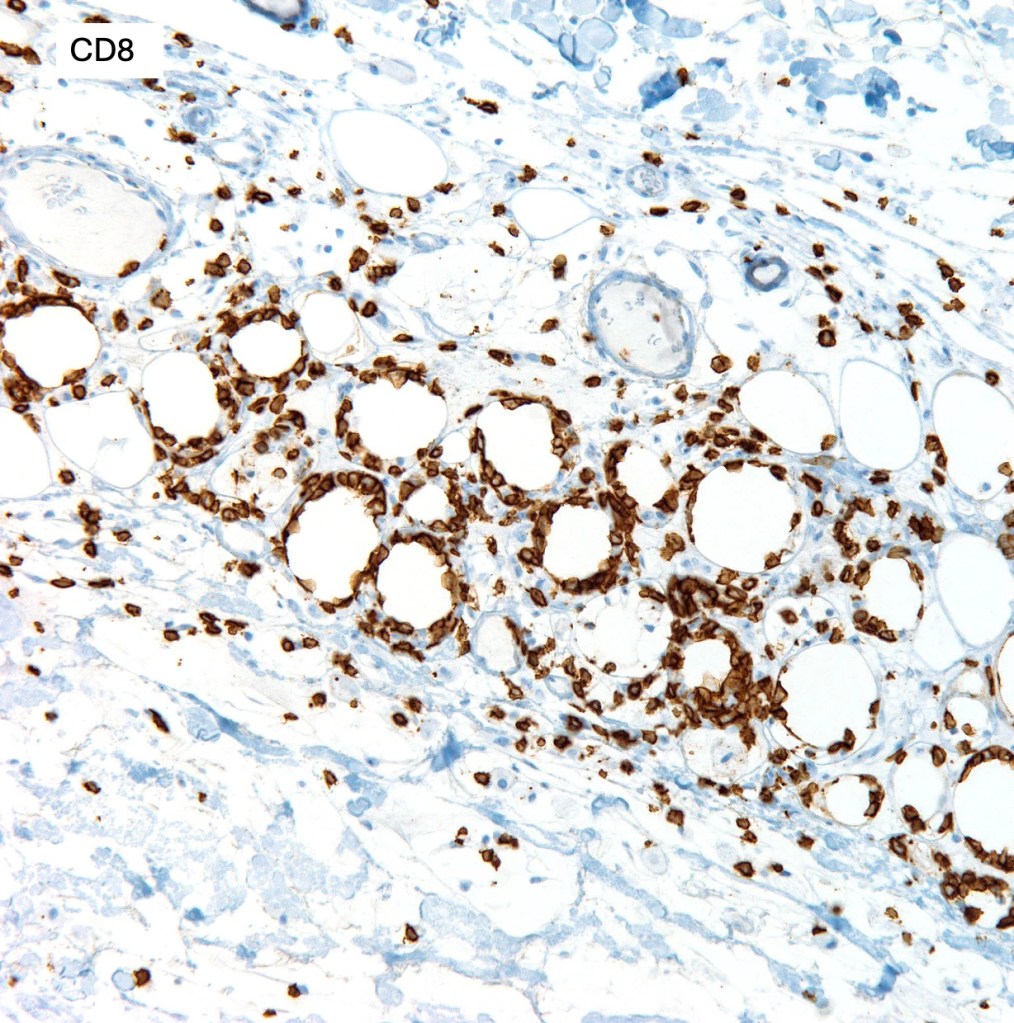

Clinical features
•Rare cutaneous lymphoma with a generally good prognosis except for patients who develop a hemophagocytosis syndrome
•2F:1M
•Wide age range, can affect children & adolescents
•Asymptomatic erythematous/violaceus nodules or deep plaques
•Limbs & trunk but may be widespread
•Variable B-symptoms in up to 50% of patients
•Anemia, cytopenia, high ESR & abnormal liver function
•Hemophagocytosis syndrome (20% of cases)
•Coexistent autoimmune disease including lupus erythematosus
•Rarely disseminated disease involving lymph nodes and bone marrow






Histological features
•Cytotoxic alpha-beta phenotype
•Dense infiltrate involving the lobules of the subcutaneous fat
•Epidermis & dermis are uninvolved
•Atypical lymphocytes with hyperchromatic nuclei & minimal cytoplasm
•Rimming of adipocytes
•Mitoses often abundant
•Fat necrosis with xanthoma cells & nuclear dust
•Variable hemophagocytosis (characteristic bean bag cells)
•CD3, CD8 & beta F1 +ve
•CD4-ve
•Variable granzyme B, TIA-1 & perforin expression
•Variable expression of CD2, CD5 & CD7
•Absence of CD123+ve plasmacytoid dendritic cells
•Ki67 can be marked
•CD30-ve
•EBV –ve
•Very occasionally interface change, mucin deposition & plasma cells overlapping lupus erythematosus panniculitis has been documented

Differential diagnosis
Cutaneous γ/δ T cell lymphoma is an important differential diagnosis as this latter is generally accosiated with a poor prognosis. It can be distinguised by a CD4-, CD8-ve beta F1-ve and CD56+ve phenotype.
Lupus erytematosus profundus/panniculitis may sometimes eneter the differential diagnosis. Features in favor of this diagnosis include epidermal interface chnage, lymphoid follicles, conspicuous plasma cells, halinization and CD123 plasmacytoid dendritic cells. There is some evidence to suggest these two conditions may be related at least in a subset of patients. Further studies are necessary to confirm this hypophysis.
Leave a comment